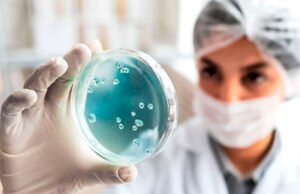
Edomex reporta primeros dos casos de viruela del mono

Tag: Estado de México
Priscila Lara, la reina de belleza de Ecatepec detenida en Europa...
Priscila Lara Guevara, reina de belleza en 2016 por el Estado de México, fue detenida en Croacia por el robo de 45 botellas de...
Edomex reporta primeros dos casos de viruela del mono
El sistema de salud del Estado de México confirmó los dos primeros casos de viruela del mono o viruela símica en pacientes mexiquenses, se...
Detienen por abuso sexual a maestro de kinder de Ecatepec,...
La Fiscalía General de Justicia del Estado de México informó que fue detenido Carlos Alberto “N”, maestro acusado de abusar sexualmente de menores de...
Canal Judicial estrena serie ‘Caníbal, indignación total’
La Suprema Corte de Justicia de la Nación (SCJN) estrenará este lunes la serie la Caníbal, indignación total. Se transmitirá a las 11 de la noche...
Aumenta a 4 mil 600 cifra de restos óseos hallados en...
El número de restos óseos ubicados en la casa del feminicida serial Andrés Filomeno Mendoza Celis ascendió a un total de 4 mil 600 restos óseos, de los...
Mono araña abatido en Texcaltitlán, Edomex, ya tiene corrido
El mono araña que fue abatido el pasado 14 de junio en Texcaltitlán ya tiene su propio corrido.
Fue a través de redes sociales que...